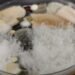
Bridging the Gap: DIY Mold Tests as Preliminary Step Before Professional Inspection

Respiratory infections are common and can be caused by a variety of factors, including bacteria, viruses, and fungi. Mold is a type of fungus that can grow in damp environments, and exposure to mold has been linked to respiratory symptoms. In some cases, exposure to mold can cause or aggravate respiratory infections.

Understanding the impact of mold on respiratory health is important for individuals who may be at risk. Mold can grow in a variety of environments, including homes, schools, and workplaces. It can cause a range of symptoms, from mild to severe, and can exacerbate existing respiratory conditions such as asthma.
If you are experiencing respiratory symptoms, it is important to consider the role that mold exposure may be playing. Seeking medical attention and taking steps to prevent and control mold growth in living spaces can help to reduce the risk of respiratory infections and other health complications.
Key Takeaways
- Mold exposure can cause or aggravate respiratory infections.
- Symptoms of mold exposure can range from mild to severe and can exacerbate existing respiratory conditions.
- Prevention and control of mold growth in living spaces is important for reducing the risk of respiratory infections and other health complications.
Understanding Mold and Its Impact on Health

Mold is a type of fungus that grows in warm, damp, and humid environments. It reproduces by releasing tiny spores into the air that can be inhaled by people. While mold is a natural part of the environment, exposure to high levels of mold spores can cause health problems, especially for people with weakened immune systems or respiratory problems.
Types of Mold and Common Habitats
There are many different types of mold, but some of the most common include aspergillus, penicillium, and stachybotrys chartarum (also known as “black mold“). These molds can be found in a variety of indoor and outdoor environments, including damp basements, bathrooms, kitchens, and areas with water damage.
How Mold Affects the Respiratory System
Mold can cause a range of respiratory problems, from mild allergic reactions to more serious infections. When mold spores are inhaled, they can trigger an immune response in the body, leading to symptoms such as coughing, wheezing, and shortness of breath. For people with allergies or asthma, exposure to mold can make their symptoms worse.
In addition, exposure to high levels of mold can cause infections in the lungs, especially in people with weakened immune systems. These infections can be serious and may require medical treatment.
Overall, it is important to take steps to prevent mold growth in your home or workplace, especially if you are at risk for respiratory problems. This includes controlling moisture levels, fixing leaks and water damage promptly, and using ventilation and air conditioning systems to reduce humidity.
Symptoms of Mold Exposure
Mold is a type of fungus that can grow in damp areas indoors and outdoors. Exposure to mold can cause a variety of symptoms in individuals, especially those with respiratory problems or compromised immune systems.
Common Symptoms of Mold-Related Illnesses
Mold allergy symptoms can be similar to those of other respiratory allergies. Common symptoms of mold-related illnesses include:
- Coughing and wheezing
- Stuffy or runny nose
- Itchy or watery eyes
- Skin rash or hives
- Headache
- Fatigue
- Fever
If an individual is exposed to mold for a prolonged period, more severe symptoms may develop. These can include shortness of breath, chest tightness, and difficulty breathing.
Identifying Severe Mold Allergy Symptoms
Severe mold allergy symptoms are rare but can be life-threatening. Anaphylaxis is a severe allergic reaction that can occur after exposure to mold. Symptoms of anaphylaxis include:
- Difficulty breathing
- Swelling of the face, lips, or tongue
- Rapid or weak pulse
- Dizziness or fainting
Individuals who experience these symptoms after exposure to mold should seek immediate medical attention.
In conclusion, mold exposure can cause a range of symptoms in individuals. While most symptoms are mild and can be treated with over-the-counter medications, severe symptoms require immediate medical attention. It is important to identify and address mold growth in homes and workplaces to prevent exposure and reduce the risk of mold-related illnesses.
Diagnosis of Mold-Related Respiratory Conditions

Mold-related respiratory conditions can be difficult to diagnose because the symptoms are similar to those of other respiratory infections. However, there are certain signs and symptoms that can indicate a mold-related respiratory condition.
When to See a Doctor
If an individual experiences persistent respiratory symptoms, such as coughing, wheezing, shortness of breath, or chest tightness, they should see a doctor. Additionally, if an individual suspects that their respiratory symptoms are related to mold exposure, they should inform their doctor.
Diagnostic Tests and Procedures
To diagnose mold-related respiratory conditions, doctors may perform a variety of tests and procedures. These may include:
- Chest X-rays: A chest X-ray can help identify any abnormalities in the lungs caused by mold exposure.
- Sputum Tests: Sputum tests involve analyzing a sample of mucus coughed up from the lungs to check for the presence of mold spores or other signs of infection.
- Bronchoscopy: A bronchoscopy involves inserting a thin, flexible tube with a camera on the end into the lungs to examine the airways. This procedure may be used to collect a sample of lung tissue for analysis.
- Allergy Testing: Allergy testing may be performed to determine if an individual has an allergic reaction to mold.
If an individual is diagnosed with a mold-related respiratory condition, treatment may involve medications such as antihistamines, decongestants, or corticosteroids. In severe cases, hospitalization may be required.
Treatment Options for Mold-Induced Respiratory Issues
Individuals with mold-induced respiratory issues may experience a range of symptoms, including coughing, wheezing, shortness of breath, and chest tightness. While avoiding exposure to mold is the most effective way to manage these symptoms, there are several treatment options available to alleviate respiratory problems caused by mold exposure.
Medications and Therapies
Antifungal medication may be prescribed to individuals with mold-induced respiratory issues caused by fungal infections. These medications work by killing or preventing the growth of fungi in the body. Examples of antifungal medications include fluconazole, itraconazole, and voriconazole.
Corticosteroids may also be prescribed to reduce inflammation and swelling caused by mold-induced respiratory issues. These medications work by suppressing the immune system and reducing the body’s inflammatory response. Examples of corticosteroids include prednisone and dexamethasone.
Bronchodilators, such as albuterol, may be used to open up the airways and improve breathing in individuals with asthma or other respiratory conditions aggravated by mold exposure. These medications work by relaxing the muscles in the airways, allowing more air to flow through.
Managing Asthma and Allergies Due to Mold
Individuals with asthma or allergies due to mold exposure may benefit from allergy shots or immunotherapy. These treatments work by gradually exposing the body to small amounts of allergens, such as mold spores, to build up immunity and reduce allergic reactions.
In addition to medication and therapy, managing mold exposure is key to reducing respiratory symptoms. This may include keeping indoor humidity levels below 50%, using air purifiers with HEPA filters, and regularly cleaning and maintaining HVAC systems.
In conclusion, individuals with mold-induced respiratory issues have several treatment options available to alleviate symptoms and manage their condition. By working with a healthcare provider and taking steps to reduce mold exposure, individuals can improve their respiratory health and quality of life.
Prevention and Control of Mold in Living Spaces

Mold can be a serious problem in living spaces, especially when it comes to respiratory infections. There are several ways to prevent and control mold growth in your home, including reducing indoor humidity and moisture, and improving ventilation and air quality.
Reducing Indoor Humidity and Moisture
One of the most important steps in preventing mold growth is to reduce indoor humidity and moisture. This can be done by using a dehumidifier in humid areas of the home, aiming to keep humidity below 50%. Additionally, fixing any leaks in the home can help reduce moisture levels, as can increasing air movement by using a fan or opening windows. It is also important to ensure that any water-damaged materials are promptly removed and replaced.
Importance of Ventilation and Air Quality
Good ventilation and air quality are also important in preventing mold growth. This can be achieved by using exhaust fans in bathrooms and kitchens, as well as ensuring that air conditioning and heating systems are properly maintained. It is also important to regularly clean and replace air filters in these systems.
The Environmental Protection Agency (EPA) recommends several additional steps for preventing and controlling mold growth, including:
- Keeping indoor humidity levels low, ideally between 30 and 60 percent.
- Using mold-resistant products in areas prone to moisture, such as bathrooms and kitchens.
- Regularly cleaning and maintaining gutters and downspouts to ensure proper drainage away from the home.
- Ensuring that the ground around the home slopes away from the foundation to prevent water from seeping into the basement or crawlspace.
By taking these steps, individuals can help prevent and control mold growth in their living spaces, reducing the risk of respiratory infections and other health problems.
Complications from Long-Term Mold Exposure
Mold exposure can lead to a range of complications, especially when it is long-term. These complications can be severe and may even lead to chronic illness. In this section, we will discuss some of the complications that can arise from long-term mold exposure.
Respiratory Infections and Chronic Illnesses
Mold spores can cause respiratory infections, such as bronchitis and pneumonia, especially in people with weakened immune systems. According to Mayo Clinic, mold exposure can also cause allergic reactions, such as sneezing, runny nose, and itchy eyes, nose, and throat. In some cases, mold exposure can lead to chronic pulmonary aspergillosis, a serious lung infection that can cause coughing, chest pain, and shortness of breath.
Mold Exposure and Immune System Compromise
Long-term exposure to mold can weaken the immune system, making it harder for the body to fight off infections. This can lead to a range of complications, including an increased risk of cancer. According to a study published in the Journal of Immunotoxicology, exposure to mold can suppress the immune system and increase the risk of cancer. In addition, people with weakened immune systems, such as those with HIV/AIDS or undergoing chemotherapy, are more susceptible to mold-related complications.
In conclusion, long-term mold exposure can lead to a range of complications, including respiratory infections, chronic illnesses, and immune system compromise. It is important to take steps to prevent mold growth in your home or workplace, such as fixing leaks and reducing humidity levels. If you suspect that you have mold in your home or workplace, it is important to have it removed by a professional.
Understanding Risk Factors and Vulnerable Populations
Respiratory infections can be caused or aggravated by mold exposure, especially in vulnerable populations. Understanding the risk factors and vulnerable populations can help individuals take appropriate preventive measures and seek timely medical attention.
Children and the Elderly
Children and the elderly are at a higher risk of developing respiratory infections due to mold exposure. Children have developing immune systems that are more susceptible to respiratory infections. Elderly individuals, on the other hand, have weakened immune systems due to aging, making them more vulnerable to respiratory infections.
Individuals with Pre-existing Health Conditions
Individuals with pre-existing health conditions such as organ transplant, cystic fibrosis, and family history of respiratory infections are also at a higher risk of developing respiratory infections due to mold exposure. These individuals have weakened immune systems, making them more vulnerable to respiratory infections.
It is important to note that not everyone who is exposed to mold will develop respiratory infections. However, individuals who are at a higher risk should take appropriate preventive measures such as avoiding mold exposure, using air purifiers, and seeking timely medical attention if they experience any symptoms of respiratory infections.
Frequently Asked Questions
What are the common indications of respiratory issues linked to mold exposure?
Respiratory issues linked to mold exposure can cause a variety of symptoms. These symptoms can include coughing, sneezing, wheezing, difficulty breathing, sore throat, headaches, and fatigue. The severity of these symptoms can vary depending on the individual and the extent of the exposure to mold.
How can mold exposure lead to a fungal lung infection?
Mold exposure can lead to a fungal lung infection when the spores of the mold are inhaled into the lungs. This can cause an infection known as aspergillosis, which can result in symptoms such as coughing, fever, and difficulty breathing. In severe cases, aspergillosis can lead to serious complications such as lung damage and even death.
What are the long-term effects of mold exposure on respiratory health?
Long-term exposure to mold can lead to chronic respiratory issues such as asthma, bronchitis, and other lung diseases. Additionally, mold exposure can weaken the immune system, making individuals more susceptible to respiratory infections and other illnesses.
Can mold exposure result in severe respiratory conditions like aspergillosis?
Yes, mold exposure can result in severe respiratory conditions such as aspergillosis. Aspergillosis is a fungal infection that can develop in individuals with weakened immune systems or those who have been exposed to high levels of mold spores.
What are the typical symptoms of mold poisoning in adults?
Symptoms of mold poisoning in adults can include respiratory issues such as coughing, wheezing, and difficulty breathing. Additionally, individuals may experience skin irritation, headaches, and fatigue. In severe cases, mold poisoning can lead to neurological issues and even death.
How can you distinguish if respiratory symptoms are a result of mold in your environment?
The best way to determine if respiratory symptoms are a result of mold in your environment is to have a professional mold inspection performed. This can help identify the presence of mold in your home or workplace and determine the extent of the exposure. Additionally, individuals may notice a musty odor or see visible signs of mold growth, such as black or green spots on walls or ceilings.